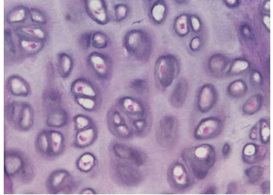

¤Loosely arranged connective tissue and cells
¤Gel-like matrix
¤Contains many collagen and elastin fibers
¤Most nuclei represent fibroblasts
¤This type of connective tissue can be found deep to skin but superficial to the muscle

Connective Tissue Proper
Areolar

Epithelial Tissue
Simple Squamous

Epithelial Tissue
Pseudostratified

Epithelial
Simple Columnar

Connective
Adipose
Cartilage
Hyaline Cartilage

Simple
Stratified squamous

Connective
Areolar

Epithelial
Simple Cuboidal

Epithelial
Transitional

Cartilage
Fibrocartilage
¤Contains densely packed bundles of collagen fibers
¤Very strong

Connective Tissue Proper
Dense Regular
¤Provide supporting framework for organs in the lymphatic system, liver and kidney

Connective
Reticular

Connective
Areolar

Epithelial
Simple Columnar

Epithelial
Transitional

Connective
Adipose

Connective
Dense Regular

Epithelial
Pseudostratified

Connective
Hyaline Cartilage

Epithelial
Stratified Squamous

Connective
Fibrocartilage

Epithelial
Simple Cuboidal

Connective
Reticular